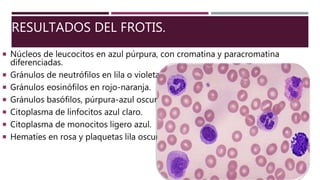
RESULTADOS DEL FROTIS.
 Núcleos de leucocitos en azul púrpura, con cromatina y paracromatina
diferenciadas.
 Gránulos de neutrófilos en lila o violeta
 Gránulos eosinófilos en rojo-naranja.
 Gránulos basófilos, púrpura-azul oscuro.
 Citoplasma de linfocitos azul claro.
 Citoplasma de monocitos ligero azul.
 Hematíes en rosa y plaquetas lila oscuro.

El documento describe el proceso para realizar un recuento diferencial de leucocitos mediante un frotis y tinción de Wright. Se detallan los materiales, el procedimiento de tinción y los resultados esperados, así como los valores normales de los diferentes tipos de leucocitos. Además, se resalta la importancia de la fijación y el adecuado manejo de las muestras para asegurar resultados precisos.